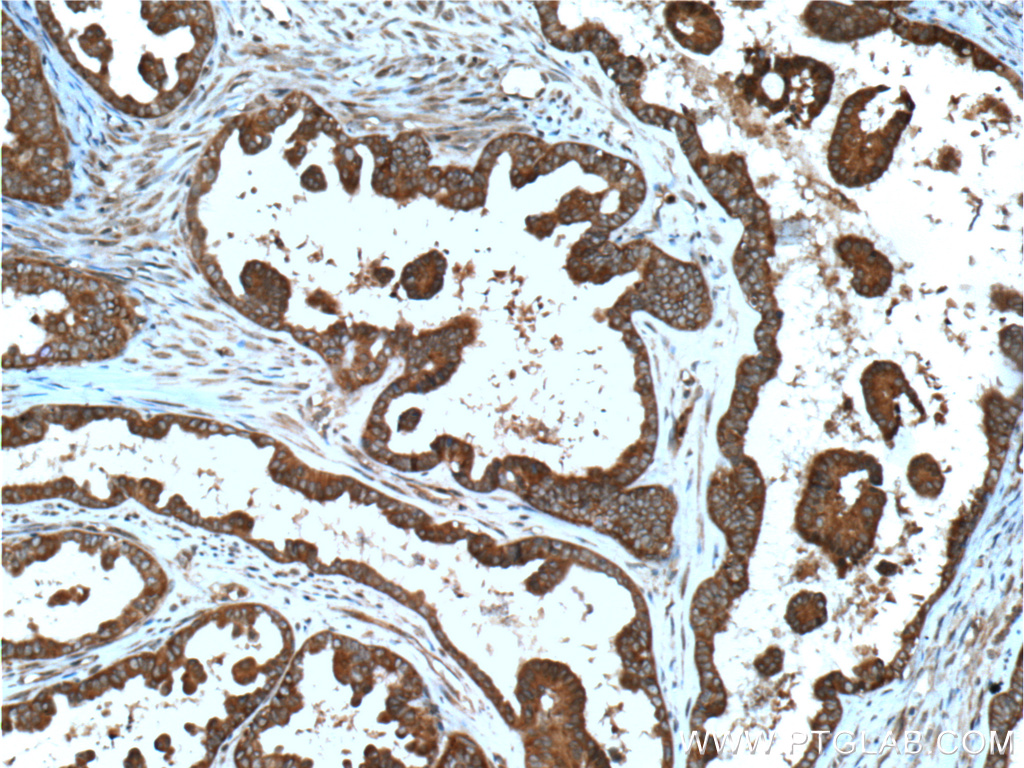

验证数据展示
经过测试的应用
| Positive WB detected in | HEK-293 cells, HEK-293T cells |
| Positive IP detected in | HeLa cells, HEK-293T cells |
| Positive IHC detected in | human ovary tumor tissue, human breast cancer tissue, human prostate cancer tissue, human skeletal muscle tissue Note: suggested antigen retrieval with TE buffer pH 9.0; (*) Alternatively, antigen retrieval may be performed with citrate buffer pH 6.0 |
| Positive IF/ICC detected in | HeLa cells |
推荐稀释比
| 应用 | 推荐稀释比 |
|---|---|
| Western Blot (WB) | WB : 1:150-1:600 |
| Immunoprecipitation (IP) | IP : 0.5-4.0 ug for 1.0-3.0 mg of total protein lysate |
| Immunohistochemistry (IHC) | IHC : 1:50-1:500 |
| Immunofluorescence (IF)/ICC | IF/ICC : 1:50-1:500 |
| It is recommended that this reagent should be titrated in each testing system to obtain optimal results. | |
| Sample-dependent, Check data in validation data gallery. | |
产品信息
21861-1-AP targets DOCK4 in WB, IHC, IF/ICC, IP, ELISA applications and shows reactivity with human samples.
| 经测试应用 | WB, IHC, IF/ICC, IP, ELISA Application Description |
| 文献引用应用 | WB, IHC, IF, IP |
| 经测试反应性 | human |
| 文献引用反应性 | human |
| 免疫原 |
CatNo: Ag16516 Product name: Recombinant human DOCK4 protein Source: e coli.-derived, PGEX-4T Tag: GST Domain: 1703-2011 aa of BC117689 Sequence: TGQSESSDEVFNMQPSPSTSSLSSTHSASPNVTSSAPSSARASPLLSDKHKHSRENSCLSPRERPCSAIYPTPVEPSQRMLFNHIGDGALPRSDPNLSAPEKAVNPTPSSWSLDSGKEAKNMSDSGKLISPPVPPRPTQTASPARHTTSVSPSPAGRSPLKGSVQSFTPSPVEYHSPGLISNSPVLSGSYSSGISSLSRCSTSETSGFENQVNEQSAPLPVPVPVPVPSYGGEEPVRKESKTPPPYSVYERTLRRPIPLPHSLSIPVTSEPPALPPKPLAARSSHLENGARRTDPGPRPRPLPRKVSQL 种属同源性预测 |
| 宿主/亚型 | Rabbit / IgG |
| 抗体类别 | Polyclonal |
| 产品类型 | Antibody |
| 全称 | dedicator of cytokinesis 4 |
| 别名 | dedicator of cytokinesis 4, KIAA0716 |
| 计算分子量 | 2011 aa, 230 kDa |
| 观测分子量 | 225 kDa |
| GenBank蛋白编号 | BC117689 |
| 基因名称 | DOCK4 |
| Gene ID (NCBI) | 9732 |
| RRID | AB_2878930 |
| 偶联类型 | Unconjugated |
| 形式 | Liquid |
| 纯化方式 | Antigen affinity purification |
| UNIPROT ID | Q8N1I0 |
| 储存缓冲液 | PBS with 0.02% sodium azide and 50% glycerol, pH 7.3. |
| 储存条件 | Store at -20°C. Stable for one year after shipment. Aliquoting is unnecessary for -20oC storage. |
背景介绍
DOCK4, originally identified as a product of a gene which is deleted during tumor progression, is a member of DOCK180 family proteins. Dock4 has been found recently to be associated with several neuropsychiatric diseases, including autism, dyslexia, and schizophrenia. Multiple studies in fibroblasts then confirmed that Dock4 is capable of controlling cell migration by transducing several upstream signals, such as Wnt, platelet-derived growth factor, and RhoG, toward activation of Rac1. Mutations in this gene have been associated with ovarian, prostate, glioma, and colorectal cancers.
实验方案
| Product Specific Protocols | |
|---|---|
| IF protocol for DOCK4 antibody 21861-1-AP | Download protocol |
| IHC protocol for DOCK4 antibody 21861-1-AP | Download protocol |
| IP protocol for DOCK4 antibody 21861-1-AP | Download protocol |
| WB protocol for DOCK4 antibody 21861-1-AP | Download protocol |
| Standard Protocols | |
|---|---|
| Click here to view our Standard Protocols |
发表文章
| Species | Application | Title |
|---|---|---|
Proc Natl Acad Sci U S A Up-regulated cytotrophoblast DOCK4 contributes to over-invasion in placenta accreta spectrum. | ||
Front Cell Dev Biol USP36-Mediated Deubiquitination of DOCK4 Contributes to the Diabetic Renal Tubular Epithelial Cell Injury via Wnt/β-Catenin Signaling Pathway. | ||
Science Multiscale photocatalytic proximity labeling reveals cell surface neighbors on and between cells | ||
Cell Oncol (Dordr) THEMIS2 contributes to ovarian cancer metastasis via DOCK4-mediated activation of Rap1 signaling | ||
Ann Med Elevated DOCK4 expression correlates with favorable prognosis and immune infiltration in clear cell renal cell carcinoma. |